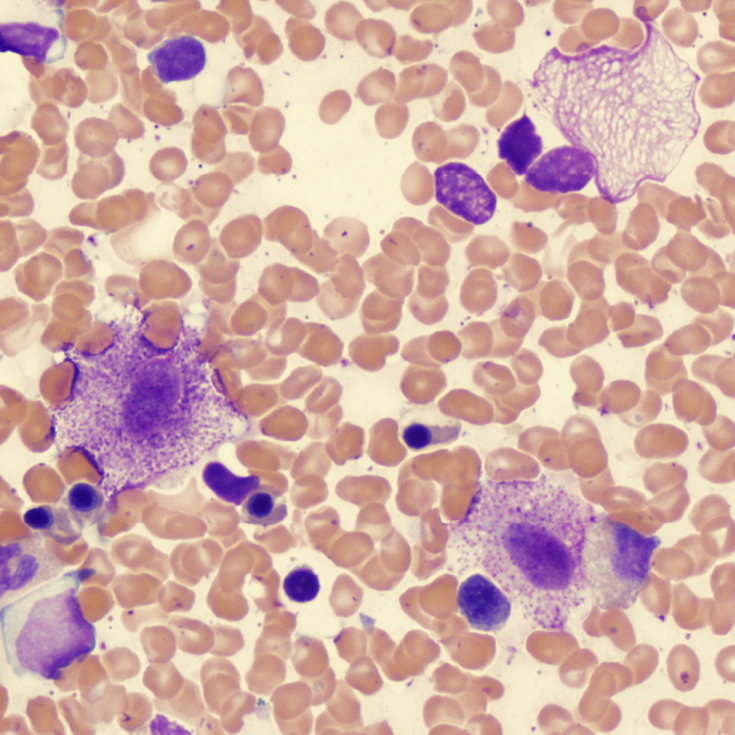
Mastocytoses

Les points clés – Mastocytoses
Les mastocytoses constituent un groupe hétérogène de maladies hématologiques, caractérisées par la prolifération et l’accumulation de mastocytes pathologiques dans un ou plusieurs organes, ainsi que par leur activation incontrôlée (dégranulation), entraînant une libération anarchique de médiateurs mastocytaires dans le sang. Ces maladies sont désormais reconnues comme plus fréquentes qu’estimé auparavant, avec une prévalence d’environ 1/3 500 personnes.1-3
La clonalité des mastocytoses repose le plus souvent sur une mutation acquise « gain de fonction » du gène KIT, codant pour le récepteur KIT à activité tyrosine-kinase. Cette mutation, retrouvée chez plus de 90 % des patients, est majoritairement de type D816V.1-4
Chez l’enfant, la mastocytose est le plus souvent cutanée, pouvant débuter dès la naissance et régressant spontanément dans au moins 60 % des cas à l’adolescence. Chez l’adulte, les formes systémiques prédominent et se caractérisent par l’infiltration de la moelle osseuse, mais aussi parfois d’autres organes tels que le tube digestif, le foie, la rate et les ganglions. L’atteinte cutanée peut être absente. Parmi les mastocytoses systémiques, environ 90 % sont indolentes, avec évolution en général lente mais symptômes chroniques possibles, tandis que 10 % correspondent à des formes avancées, incluant la mastocytose systémique agressive, la leucémie à mastocytes et les mastocytoses associées à d’autres hémopathies malignes, associées à un pronostic défavorable.1-3,5-9
Pour en savoir plus sur les mastocytoses, retrouvez les explications du Dr Rossignol sur RARE à l’écoute, le podcast dédié aux maladies rares, en cliquant ici.
Les manifestations cliniques sont variables et dépendent du type de mastocytose et de l’activation mastocytaire. Les formes systémiques peuvent s’accompagner de lésions cutanées maculo-papuleuses, souvent pigmentées et prurigineuses, avec parfois le signe de Darier (gonflement et rougeur après frottement). Les signes d’activation mastocytaire incluent flushs, prurit, douleurs abdominales, diarrhées, reflux, symptômes respiratoires (bronchospasme, toux chronique), manifestations ORL (rhinite, congestion nasale), troubles urinaires et anaphylaxies. Une ostéoporose précoce ou des fractures vertébrales à faible traumatisme peuvent également survenir. Les formes avancées se distinguent par une altération de l’état général, une perte de poids importante, des diarrhées sévères avec malabsorption et hypoalbuminémie, des organomégalies (hépatomégalie, ascite, splénomégalie), des cytopénies et des anomalies hématologiques évoquant une hémopathie associée.1-3,5-8
La physiopathologie repose sur la prolifération clonale de mastocytes porteurs de la mutation KIT, entraînant une activation constitutive du récepteur KIT et une libération massive de médiateurs (histamine, tryptase, leucotriènes, et héparine). Cette activation inappropriée explique à la fois les manifestations systémiques et locales de la maladie.1-2,8
Le diagnostic repose sur la combinaison de critères cliniques, biologiques, histologiques et moléculaires. La biopsie de la moelle osseuse ou d’un organe infiltré révèle un infiltrat dense de mastocytes atypiques, exprimant CD2, CD25 et/ou CD30, avec souvent la mutation KIT D816V. Le dosage sérique de tryptase (> 20 µg/L) constitue un critère supplémentaire. La mastocytose systémique avancée est retenue en présence de critères de gravité, tels que cytopénies, atteintes hépatiques ou spléniques, malabsorption sévère ou ostéolyse pathologique.1-2,5-9
Le traitement des mastocytoses repose sur une prise en charge individualisée, adaptée au type de maladie et à la sévérité des symptômes. Il associe des mesures préventives pour limiter les facteurs déclenchants d’activation mastocytaire, un traitement symptomatique visant à contrôler les manifestations liées à la libération de médiateurs mastocytaires (antihistaminiques, stabilisateurs de membrane mastocytaire, traitements digestifs ou respiratoires), et, lorsque cela est indiqué, un traitement étiologique destiné à réduire l’infiltration mastocytaire et améliorer la survie. Les options étiologiques incluent des inhibiteurs de tyrosine-kinase ciblant le récepteur KIT muté et, dans certains cas, la greffe allogénique de cellules souches hématopoïétiques. La décision thérapeutique doit être discutée dans le cadre d’une concertation multidisciplinaire, idéalement lors d’une RCP nationale Mastocytose.1-3,5-9
La prise en charge des mastocytoses nécessite une approche multidisciplinaire adaptée à l’évolution de la maladie et passe par des spécialistes : hématologues, dermatologues, gastro-entérologues, anesthésistes, allergologues, médecins traitants et autres spécialistes selon les organes touchés et la sévérité de la maladie.1-2
La prise en charge inclut également l’éducation thérapeutique du patient, avec information sur les facteurs déclenchants, formation à l’usage des auto-injecteurs d’adrénaline et remise d’une carte spécifique (telle que la carte CEREMAST) mentionnant le diagnostic et les consignes d’urgence.1-10
Références
- PNDS – Mastocytoses avancées de l’adulte (Juillet 2025) : https://www.has-sante.fr/upload/docs/application/pdf/2025-07/pnds_mastocytoses_avancees_valide.pdf
- PNDS – Mastocytoses non-avancées chez l’adulte (Juillet 2022) : https://www.has-sante.fr/upload/docs/application/pdf/2022-07/synthese_mg_mastocytoses_non_avancees_chez_l_adulte.pdf
- Filière MaRIH – Mastocytoses : https://marih.fr/pathologies/mastocytoses/
- Andreas Reiter et al. New developments in diagnosis, prognostication, and treatment of advanced systemic mastocytosis. Blood. 2020 Apr 16;135(16):1365-1376.
- Orphanet – Mastocytose systémique : https://www.orpha.net/fr/disease/detail/2467#:~:text=Groupe%20h%C3%A9t%C3%A9rog%C3%A8ne%20d’h%C3%A9mopathies%20malignes,associ%C3%A9es%20%C3%A0%20une%20atteinte%20cutan%C3%A9e.
- Orphanet – Mastocytose systémique indolente : https://www.orpha.net/fr/disease/detail/98848
- Orphanet – Mastocytose cutanée : https://www.orpha.net/fr/disease/detail/66646
- Manuel MSD, version pour les professionnels de la santé – Mastocytose et syndrome d’activation des mastocytes : https://www.msdmanuals.com/fr/professional/immunologie-troubles-allergiques/r%C3%A9actions-allergiques-auto-immunes-et-autres-r%C3%A9actions-d-hypersensibilit%C3%A9/mastocytose-et-syndrome-d-activation-des-mastocytes
- Michel Arock. New diagnostic criteria for mastocytosis: Progresses but still pending questions. Bull Acad Natl Med 208 (2024) 810—823.
- Hôpital Necker-Enfants malades « 100 questions / réponses sur la mastocytose » : https://maladiesrares-necker.aphp.fr/100-questions-reponses-sur-la-mastocytose/
Les symptômes des mastocytoses
Les mastocytoses se manifestent par un ensemble de signes cliniques polymorphes, reflétant à la fois l’infiltration tissulaire par les mastocytes et la libération excessive de leurs médiateurs. Leur expression varie selon le type de mastocytose :1-7
- Lésions cutanées : maculo-papules pigmentées et prurigineuses, parfois déclenchant un gonflement et une rougeur après frottement (signe de Darier).
- Signes d’activation mastocytaire : flushs, prurit, urticaire, rougeurs soudaines, parfois associés à des troubles digestifs tels que douleurs abdominales, diarrhées ou reflux.
- Manifestations respiratoires ou ORL : bronchospasme, toux chronique, rhinite ou congestion nasale pouvant être intermittentes ou persistantes.
- Troubles urinaires : pollakiurie ou douleurs vésicales en lien avec l’activation mastocytaire.
- Anaphylaxies : réactions parfois sévères, spontanées ou déclenchées (alimentaire, médicamenteuse, venins d’hyménoptères), pouvant être inaugurales.
- Atteintes osseuses : ostéoporose précoce ou fractures vertébrales à faible traumatisme.
- Signes systémiques dans les formes avancées : altération de l’état général, amaigrissement, malabsorption avec diarrhées sévères et hypoalbuminémie, organomégalies (hépatomégalie, ascite, splénomégalie), cytopénies ou anomalies biologiques évocatrices d’une hémopathie associée.
Pour en savoir plus sur les mastocytoses, retrouvez les explications du Dr Livideanu sur RARE à l’écoute, le podcast dédié aux maladies rares, en cliquant ici.
Références
- PNDS – Mastocytoses avancées de l’adulte (Juillet 2025) : https://www.has-sante.fr/upload/docs/application/pdf/2025-07/pnds_mastocytoses_avancees_valide.pdf
- PNDS – Mastocytoses non-avancées chez l’adulte (Juillet 2022) : https://www.has-sante.fr/upload/docs/application/pdf/2022-07/synthese_mg_mastocytoses_non_avancees_chez_l_adulte.pdf
- Filière MaRIH – Mastocytoses : https://marih.fr/pathologies/mastocytoses/
- Orphanet – Mastocytose systémique : https://www.orpha.net/fr/disease/detail/2467#:~:text=Groupe%20h%C3%A9t%C3%A9rog%C3%A8ne%20d’h%C3%A9mopathies%20malignes,associ%C3%A9es%20%C3%A0%20une%20atteinte%20cutan%C3%A9e.
- Orphanet – Mastocytose systémique indolente : https://www.orpha.net/fr/disease/detail/98848
- Orphanet – Mastocytose cutanée : https://www.orpha.net/fr/disease/detail/66646
- Manuel MSD, version pour les professionnels de la santé – Mastocytose et syndrome d’activation des mastocytes : https://www.msdmanuals.com/fr/professional/immunologie-troubles-allergiques/r%C3%A9actions-allergiques-auto-immunes-et-autres-r%C3%A9actions-d-hypersensibilit%C3%A9/mastocytose-et-syndrome-d-activation-des-mastocytes
Diagnostic des mastocytoses
Le diagnostic des mastocytoses repose sur un ensemble d’arguments cliniques, biologiques, histologiques et moléculaires permettant de confirmer l’infiltration mastocytaire et son caractère clonale. Il s’appuie notamment sur :1-9
- La biopsie de la moelle osseuse ou d’un organe infiltré, mettant en évidence un infiltrat dense de mastocytes atypiques exprimant des marqueurs spécifiques (CD2, CD25 et/ou CD30) et la mutation KIT, le plus souvent de type D816V.
- Les analyses moléculaires, permettant de détecter la mutation KIT D816V, retrouvée chez la majorité des patients.
- Le dosage sérique de tryptase, dont un taux supérieur à 20 µg/L constitue un critère diagnostique majeur.
- Les critères de gravité, utilisés pour identifier une mastocytose systémique avancée, tels que cytopénies, atteinte hépatique ou splénique, malabsorption sévère ou lésions osseuses lytiques.
Les données cliniques et biologiques viennent compléter ces examens, permettant de préciser le type de mastocytose et de guider la stratégie thérapeutique.
Pour en savoir plus sur les mastocytoses, retrouvez les explications du Pr Arock sur RARE à l’écoute, le podcast dédié aux maladies rares, en cliquant ici.
Références
- PNDS – Mastocytoses avancées de l’adulte (Juillet 2025) : https://www.has-sante.fr/upload/docs/application/pdf/2025-07/pnds_mastocytoses_avancees_valide.pdf
- PNDS – Mastocytoses non-avancées chez l’adulte (Juillet 2022) : https://www.has-sante.fr/upload/docs/application/pdf/2022-07/synthese_mg_mastocytoses_non_avancees_chez_l_adulte.pdf
- Orphanet – Mastocytose systémique : https://www.orpha.net/fr/disease/detail/2467#:~:text=Groupe%20h%C3%A9t%C3%A9rog%C3%A8ne%20d’h%C3%A9mopathies%20malignes,associ%C3%A9es%20%C3%A0%20une%20atteinte%20cutan%C3%A9e.
- Orphanet – Mastocytose systémique indolente : https://www.orpha.net/fr/disease/detail/98848
- Orphanet – Mastocytose cutanée : https://www.orpha.net/fr/disease/detail/66646
- Manuel MSD, version pour les professionnels de la santé – Mastocytose et syndrome d’activation des mastocytes : https://www.msdmanuals.com/fr/professional/immunologie-troubles-allergiques/r%C3%A9actions-allergiques-auto-immunes-et-autres-r%C3%A9actions-d-hypersensibilit%C3%A9/mastocytose-et-syndrome-d-activation-des-mastocytes
- Michel Arock. New diagnostic criteria for mastocytosis: Progresses but still pending questions. Bull Acad Natl Med 208 (2024) 810—823.
- Cristina Bulai Livideanu et al. French guidelines for the management of nonadvanced mastocytosis in adults. Orphanet J Rare Dis. 2025 Oct 2;20(1):499.
- Daniela Cilloni et al. Detection of KIT Mutations in Systemic Mastocytosis: How, When, and Why. Int J Mol Sci. 2024 Oct 10;25(20):10885.
Les diagnostics différentiels des mastocytoses
Poser le diagnostic de mastocytose ou de syndrome d’activation mastocytaire nécessite d’écarter :1
- Pathologies endocriniennes : phéochromocytome, vipome, gastrinome, hyperthyroïdie ou anomalies hormonales, responsables de flushes, diarrhées ou variations tensionnelles mimant une activation mastocytaire.
- Syndromes tumoraux : lymphomes, myélome, histiocytoses, tumeurs osseuses ou syndrome carcinoïde, pouvant provoquer flushes, douleurs osseuses ou symptômes systémiques similaires.
- Atteintes gastro-intestinales : ulcère, infection à Helicobacter pylori, colite ulcéreuse, maladie cœliaque, parasitoses, malabsorption ou lithiases biliaires, expliquant diarrhées, douleurs ou malaises.
- Allergies ou hypersensibilités : allergie alimentaire et anaphylaxie idiopathique, responsables de réactions aiguës pouvant être confondues avec une dégranulation mastocytaire.
- Pathologies cardiovasculaires ou systémiques : cardiopathies, hypertension, vascularites, syndrome hyperéosinophilique ou porphyrie aiguë intermittente, pouvant entraîner des symptômes vasomoteurs ou systémiques proches.
Références
- PNDS – Mastocytoses avancées de l’adulte (Juillet 2025) : https://www.has-sante.fr/upload/docs/application/pdf/2025-07/pnds_mastocytoses_avancees_valide.pdf
La prise en charge des mastocytoses1-9
La prise en charge des mastocytoses repose sur une combinaison d’approches symptomatiques, préventives et étiologiques, adaptées au type et à la sévérité de la maladie. Les mesures préventives visent à limiter les épisodes d’activation mastocytaire et les réactions anaphylactiques, en informant le patient sur les facteurs déclenchants, l’importance de l’éducation thérapeutique et l’utilisation de dispositifs d’urgence. Il est recommandé que chaque patient dispose d’une carte spécifique, telle que la carte CEREMAST proposée par la filière MARIH, mentionnant le diagnostic, les coordonnées du médecin référent et les consignes en situation d’urgence.
Le traitement symptomatique comprend principalement les antihistaminiques (anti-H1 et anti-H2), les stabilisateurs de membrane mastocytaire et, si nécessaire, d’autres mesures visant à contrôler les manifestations digestives, cutanées ou respiratoires. Les patients à risque élevé d’anaphylaxie doivent disposer d’auto-injecteurs d’adrénaline et être formés à leur utilisation.
Le traitement étiologique, lorsqu’il est indiqué, a pour objectif de réduire l’infiltration mastocytaire, d’améliorer la qualité de vie et, dans certains cas, de prolonger la survie. Il inclut l’utilisation d’inhibiteurs de tyrosine-kinase ciblant le récepteur muté KIT et, dans certains cas sélectionnés, la greffe de cellules souches hématopoïétiques allogéniques. La stratégie thérapeutique doit être individualisée, prenant en compte le type de mastocytose, la présence éventuelle d’une hémopathie associée et décidée dans le cadre d’une concertation multidisciplinaire, idéalement au sein d’une RCP nationale Mastocytose.
Pour en savoir plus sur les mastocytoses, retrouvez les explications du Dr Gourguechon sur RARE à l’écoute, le podcast dédié aux maladies rares, en cliquant ici.
Références
- PNDS – Mastocytoses avancées de l’adulte (Juillet 2025) : https://www.has-sante.fr/upload/docs/application/pdf/2025-07/pnds_mastocytoses_avancees_valide.pdf
- PNDS – Mastocytoses non-avancées chez l’adulte (Juillet 2022) : https://www.has-sante.fr/upload/docs/application/pdf/2022-07/synthese_mg_mastocytoses_non_avancees_chez_l_adulte.pdf
- Filière MaRIH – Mastocytoses : https://marih.fr/pathologies/mastocytoses/
- Orphanet – Mastocytose systémique : https://www.orpha.net/fr/disease/detail/2467#:~:text=Groupe%20h%C3%A9t%C3%A9rog%C3%A8ne%20d’h%C3%A9mopathies%20malignes,associ%C3%A9es%20%C3%A0%20une%20atteinte%20cutan%C3%A9e.
- Orphanet – Mastocytose systémique indolente : https://www.orpha.net/fr/disease/detail/98848
- Orphanet – Mastocytose cutanée : https://www.orpha.net/fr/disease/detail/66646
- Manuel MSD, version pour les professionnels de la santé – Mastocytose et syndrome d’activation des mastocytes : https://www.msdmanuals.com/fr/professional/immunologie-troubles-allergiques/r%C3%A9actions-allergiques-auto-immunes-et-autres-r%C3%A9actions-d-hypersensibilit%C3%A9/mastocytose-et-syndrome-d-activation-des-mastocytes
- Michel Arock. New diagnostic criteria for mastocytosis: Progresses but still pending questions. Bull Acad Natl Med 208 (2024) 810—823.
- Hôpital Necker-Enfants malades « 100 questions / réponses sur la mastocytose » : https://maladiesrares-necker.aphp.fr/100-questions-reponses-sur-la-mastocytose/
La parole aux patients atteints des mastocytoses
Afin d’améliorer la prise en charge et le suivi des patients atteints de mastocytoses, il est important de sensibiliser le grand public à cette maladie rare et les professionnels de santé au diagnostic et à la prise en charge adaptée.1-2
Améliorer l’information des patients et des professionnels de santé pour faciliter le diagnostic et optimiser la prise en charge des patients, sont les objectifs des Filières de Santé Maladies Rares, des Centres de Référence Maladies Rares, et des réseaux européens qui apportent leur savoir-faire et leur expertise. Pour les mastocytoses, la filière MaRIH, Filière des Maladies Rares Immuno-Hématologiques, et CEREMAST, Centre de référence des mastocytoses, sont en 1ère ligne.3-4
Au-delà de l’accompagnement des malades dans le parcours de soins, les associations de patients comme l’Association française des patients atteints de maladies du mastocyte (ASSOMAST), a pour missions de :5
- Apporter un soutien moral aux malades et à leurs familles.
- Informer et orienter les personnes concernées par les maladies du mastocyte.
- Représenter et défendre les patients auprès des acteurs de la santé.
- Améliorer la reconnaissance, le diagnostic et la prise en charge de ces maladies.
- Contribuer à la diffusion des connaissances et au développement de la recherche.
Pour en savoir plus sur les mastocytoses, écoutez le témoignage de Mme Gabilly sur RARE à l’écoute, le podcast dédié aux maladies rares, en cliquant ici.
Références
- PNDS – Mastocytoses avancées de l’adulte (Juillet 2025) : https://www.has-sante.fr/upload/docs/application/pdf/2025-07/pnds_mastocytoses_avancees_valide.pdf
- PNDS – Mastocytoses non-avancées chez l’adulte (Juillet 2022) : https://www.has-sante.fr/upload/docs/application/pdf/2022-07/synthese_mg_mastocytoses_non_avancees_chez_l_adulte.pdf
- Filière MaRIH : https://marih.fr/
- CEREMAST : https://marih.fr/groupe-experts/ceremast-centre-de-reference-des-mastocytoses/
- Association de patients ASSOMAST : https://assomast.org/
Les spécialistes des mastocytoses
Pour plus d’informations sur les mastocytoses, vous pouvez consulter les articles, vidéos et sites web ci-dessous :
- Filière MaRIH : https://marih.fr/
- CEREMAST : https://marih.fr/groupe-experts/ceremast-centre-de-reference-des-mastocytoses/
- Association de patients ASSOMAST : https://assomast.org/
- Société Française d’Hématologie (SFH) : https://sfh.hematologie.net/
- Société Française de Dermatologie (SFD) : https://www.sfdermato.org/
- Société Française de Dermatologie Pédiatrique (SFDP) : https://www.sfdp.org/
- Société Française d’Allergologie (SFA) : https://sfa.lesallergies.fr/
- PNDS – Mastocytoses avancées de l’adulte (Juillet 2025) : https://www.has-sante.fr/upload/docs/application/pdf/2025-07/pnds_mastocytoses_avancees_valide.pdf
- PNDS – Mastocytoses non-avancées chez l’adulte (Juillet 2022) : https://www.has-sante.fr/upload/docs/application/pdf/2022-07/synthese_mg_mastocytoses_non_avancees_chez_l_adulte.pdf
- Orphanet – Mastocytose systémique : https://www.orpha.net/fr/disease/detail/2467#:~:text=Groupe%20h%C3%A9t%C3%A9rog%C3%A8ne%20d’h%C3%A9mopathies%20malignes,associ%C3%A9es%20%C3%A0%20une%20atteinte%20cutan%C3%A9e.
- Orphanet – Mastocytose systémique : https://www.orpha.net/fr/disease/detail/2467#:~:text=Groupe%20h%C3%A9t%C3%A9rog%C3%A8ne%20d’h%C3%A9mopathies%20malignes,associ%C3%A9es%20%C3%A0%20une%20atteinte%20cutan%C3%A9e.
- Orphanet – Mastocytose systémique indolente : https://www.orpha.net/fr/disease/detail/98848
- Orphanet – Mastocytose cutanée : https://www.orpha.net/fr/disease/detail/66646
- Manuel MSD, version pour les professionnels de la santé – Mastocytose et syndrome d’activation des mastocytes : https://www.msdmanuals.com/fr/professional/immunologie-troubles-allergiques/r%C3%A9actions-allergiques-auto-immunes-et-autres-r%C3%A9actions-d-hypersensibilit%C3%A9/mastocytose-et-syndrome-d-activation-des-mastocytes
- Hôpital Necker-Enfants malades « 100 questions / réponses sur la mastocytose » : https://maladiesrares-necker.aphp.fr/100-questions-reponses-sur-la-mastocytose/
- Michel Arock. New diagnostic criteria for mastocytosis : Progresses but still pending questions. Bull Acad Natl Med 208 (2024) 810—823.
- Cristina Bulai Livideanu et al. French guidelines for the management of nonadvanced mastocytosis in adults. Orphanet J Rare Dis. 2025 Oct 2;20(1):499.
- Daniela Cilloni et al. Detection of KIT Mutations in Systemic Mastocytosis: How, When, and Why. Int J Mol Sci. 2024 Oct 10;25(20):10885.
- Andreas Reiter et al. New developments in diagnosis, prognostication, and treatment of advanced systemic mastocytosis. Blood. 2020 Apr 16;135(16):1365-1376.